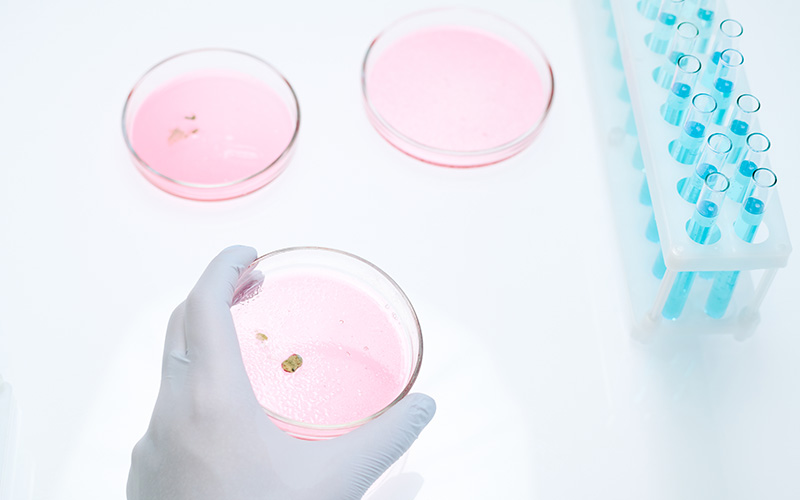

Información general
¿Qué es la
Gestación Subrogada?
La gestación subrogada también conocida como maternidad subrogada o los mal llamados «vientres de alquiler» (término con el que no estamos de acuerdo) es la técnica de reproducción asistida por la que una mujer gesta un hijo para otra persona o pareja; es decir para unos padres de intención.

Hay dos tipos de subrogación dependiendo de la relación genética de la madre gestante con el hijo:

Gestación por sustitución parcial
En este tipo de subrogación, la madre gestante aporta material genético; es decir aporta sus propios óvulos y esto quiere decir que tiene un vínculo genético con el hijo. La fecundación se realiza mediante inseminación artificial. La inseminación artificial es la técnica aplicada en el caso de la subrogación tradicional o parcial.
Los métodos más simples de inseminación artificial (tanto con semen de la pareja como de donante) consisten en observar cuidadosamente el ciclo menstrual de la mujer, depositando el semen en su vagina justo cuando un óvulo es liberado. Procedimientos más complicados, como depositar los espermatozoides directamente en el útero, son empleados según cada caso y aumentan la probabilidad de que la fecundación tenga éxito.
Gestación subrogada gestacional
En este tipo de subrogación, la madre gestante no aporta material genético; por lo que no tiene ninguna vinculación genética con el hijo. La fecundación se realiza mediante la técnica de fecundación in vitro donde los óvulos y el esperma provienen normalmente de la madre y padre intencional o de una donante.
Fecundación in vitro FIV o técnica por la cual la fecundación de los ovocitos por los espermatozoides se realiza fuera del cuerpo de la madre. El proceso implica el control hormonal del proceso ovulatorio, extrayendo uno o varios ovocitos de los ovarios maternos, para permitir que sean fecundados por espermatozoides en un medio líquido. El ovocito fecundado puede entonces ser transferido al útero de la mujer, en vistas a que anide en el útero y continúe su desarrollo hasta el parto.
Esta técnica consiste en extraer los óvulos, fecundarlos en el laboratorio y posteriormente transferirlos al útero de la gestante.
- Se realiza la estimulación ovárica mediante fármacos que van a inducir a una superovulación (entre 10 y 12 óvulos) para tener más posibilidades de éxito. Una vez los folículos están maduros se programa la extracción de los óvulos.
- Se realiza la aspiración de los folículos; se lleva a cabo mediante una punción ovárica que se controla por ecografía en el quirófano y se aplica una sedación suave. Una vez extraído el líquido folicular se envía al laboratorio para localizar los óvulos y para ello se realiza una estimación de la calidad y madurez de los mismos.
- Se fertilizan los óvulos para el cultivo de embriones. El mismo día que se produce la extracción Se hace la unión óvulo-espermatozoide; por lo que es imprescindible la donación de una muestra de semen por parte del padre de intención. Se introduce un espermatozoide (el de mejor calidad) dentro de cada óvulo; esta técnica se denomina Microinyección espermática y se realiza bajo microscopio.
Una vez transcurridas unas 20 horas se sabe el número de óvulos fecundados, y tras algunas horas más en cultivo, los óvulos fertilizados comienzan a dividirse y se produce el desarrollo embrionario. Posteriormente se programa el día de la transferencia embrionaria. - Se procede a la transferencia embrionaria; mediante una cánula de plástico se transfieren los embriones y se introducen en el útero de la gestante; todo ello se controla a través de ecografía para asegurarse que se deposita en el lugar idóneo.
Obten más información sobre la Gestación Subrogada
Aspectos psicológicos sobre la Gestación Subrogada

Gestación por sustitución parcial
En estos procesos de gestación subrogada los deseos de ser padres deben primar por encima de todo.
Cada caso tiene unas peculiaridades personales: cuando se diagnostica una infertilidad tanto en el hombre como en la mujer, o cualquier otra problemática; ocasiona un gran derrumbe emocional, genera un sufrimiento psíquico, ansiedad, sentimientos de culpabilidad, tristeza, envidia o celos hacia aquellas personas que sí pueden quedarse embarazados y tener un bebé. Suelen aparecer episodios de una autoestima baja.
En todos estos casos, el papel de los padres intencionales en la gestación subrogada juega un papel muy importante. Debemos pensar e imaginar que nosotros como padres de intención tenemos un gran deseo de ser padres y la gran mayoría ya venimos de largos y costosos procesos y tratamientos de fertilidad donde no hemos podido llevar a cabo nuestro objetivo lo que suele crear un estado de ansiedad y en ocasiones estadios depresivos.
Otros de los aspectos psicológicos a los que nos podemos enfrentar los padres intencionales son:
- Incertidumbre y miedos; si a mi hijo lo gesta otra mujer ¿será ella la madre?; No. La mujer que geste a nuestro hijo no será la madre; ya que siempre en estos procesos la gestante nunca aporta material genético por lo tanto no es hijo biológico suyo; es meramente el útero que cobija a nuestro hijo para que se desarrolle lo mejor posible y dé a luz a nuestro bebé.
- Angustia: ¿Saldrá todo bien? Debemos ser positivos y confiar en que todo saldrá bien pero siempre bajo las expectativas reales que nos vayan dando e indicando a lo largo del proceso.
- Estrés: Hay muchas situaciones que nos causan estrés en nuestra vida diaria; los estudios, el trabajo, la familia, etc. Por lo tanto, iniciar un proceso de gestación subrogada; que es o será posiblemente lo más importante que hagamos en nuestra vida, pues también puede crearnos episodios de estrés; pero todo se puede gestionar bien y superar estos episodios sin ningún problema.
- En algunos casos tendremos conflictos morales o de religión. Dependiendo de nuestras creencias.
Se trata de un proceso complicado en el que intervienen muchos sentimientos, dudas pero que se pueden ir resolviendo durante lo que dura el proceso. No deja de ser igual que los padres que se quedan embarazados biológicamente y que también se enfrentan a los miedos del embarazo, de que todo salga bien, de que el bebé nazca sano, etc. También las parejas o personas que optan por la adopción pasan por fases de sufrimiento e inseguridad debido a los largos plazos de espera, estudios de idoneidad, psicológicos y legales hasta que es firme la adopción.
Es aconsejable que todas estas inquietudes se vayan solventando a lo largo del proceso y que se vaya informando con un buen asesoramiento tanto jurídico, médico, como psicológico.

